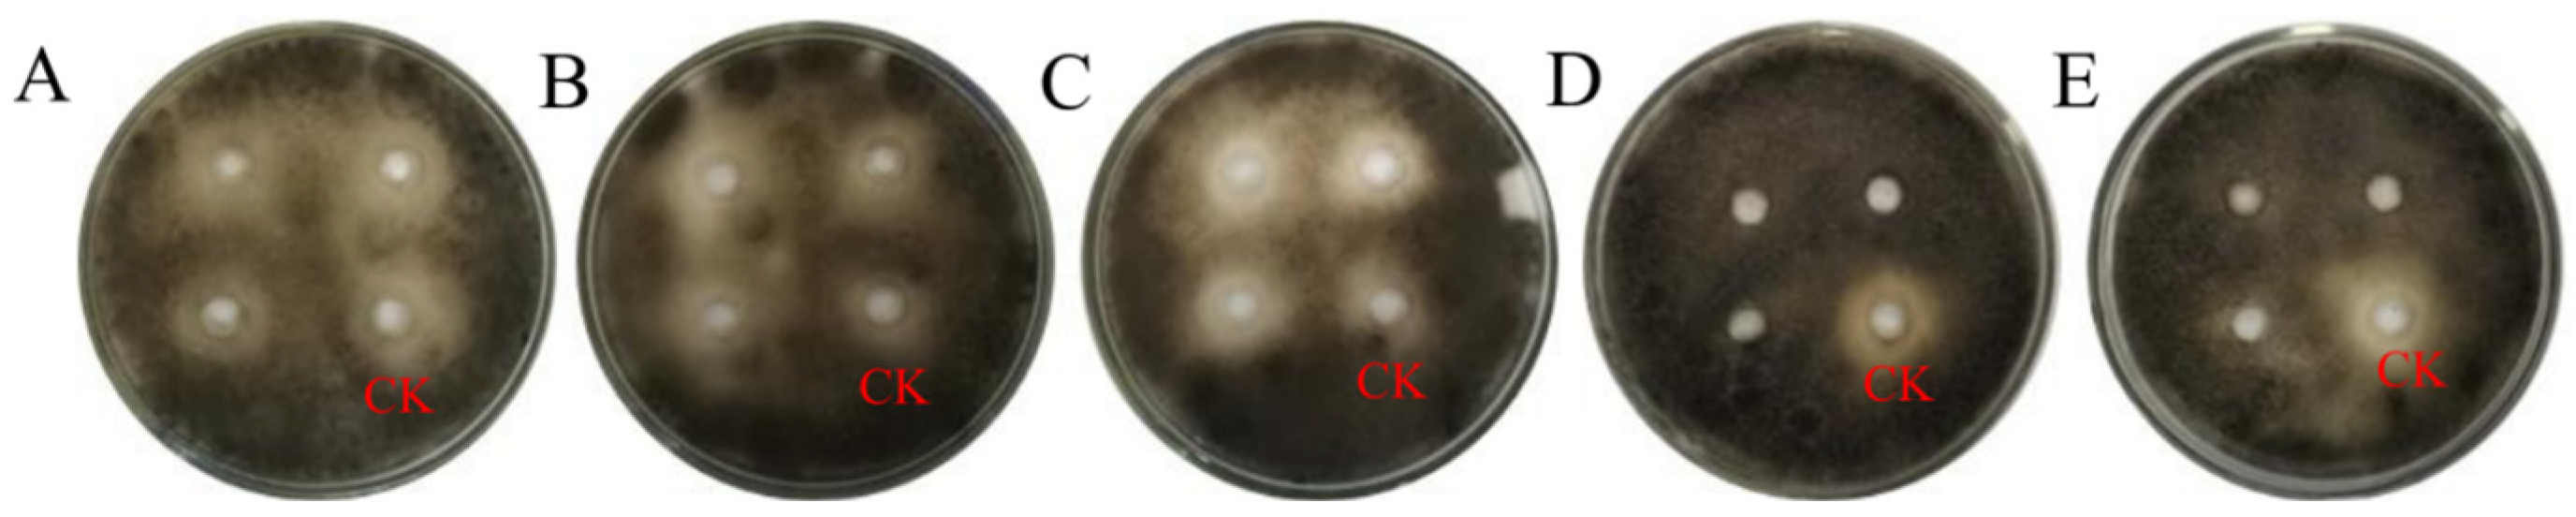
Forests 15 01605 g007

Potential of Crude Extract of Streptomyces sp. nov., Strain TRM76147 for Control of A. gaisen
Abstract
:1. Introduction
2. Materials and Methods
2.1. Strains TRM76147 and A. gaisen Were Obtained
2.2. 16S rRNA Gene and Multilocus Sequence Analysis (MLSA) Phylogeny
2.3. Polyphasic Isolation and Characterization of Strain TRM76147
2.3.1. Culture Characteristics of TRM76147
2.3.2. Peptidoglycan, Amino Acids, and Polar Lipids of TRM76147
2.4. Genomic Metabolic Potential Analysis of TRM76147
2.5. Stability Analysis of Active Crude Extract of Strain TRM76147
2.6. TRM76147 Exploration of the Mechanism of Inhibition of A. gaisen by Crude Extracts and Assessment of Bioprophylactic Potential of Pears
2.6.1. Investigation of the Mechanism of Inhibition of A. gaisen by the Crude Extract of TRM76147
2.6.2. Evaluation for Plant Pathogen Suppression Ability
2.7. Statistical Analysis
3. Results
3.1. Genetic Analysis of Strain TRM76147
3.2. Growth and Cultural Characteristics of Strain TRM76147 Compared with Reference Strains
Characterization of the Chemical Components of Bacterial Cell Walls
3.3. Analysis of Secondary Metabolites in TRM76147 Strain Using antiSMASH and bigSCAPE Software
3.4. Strain 76147 Antimicrobial Activity Analysis
3.4.1. Investigation of Fungistatic Effects of Streptomyces TRM76147 on A. gaisen Using Stepwise Extraction Method
3.4.2. Impact of Temperature on Antifungal Efficacy of TRM76147 Fermentation Crude Extract
3.4.3. Stability and Activity of TRM76147 Extract under UV and pH Conditions
3.5. Effect of Crude Extract of Strain 76147 on the Activity of A. gaisen
3.5.1. Impact of TRM76147 Compounds on A. gaisen Mycelium and Conidium Integrity
3.5.2. Impact of TRM76147 Fermentation Broth on A. gaisen Growth
4. Discussions
5. Conclusions
Supplementary Materials
Author Contributions
Funding
Data Availability Statement
Conflicts of Interest
References
- Wang, X.; Qiao, Q.; Zhao, K.; Zhai, W.; Zhang, F.; Dong, H.; Lin, L.; Xing, C.; Su, Z.; Pan, Z.; et al. PbWRKY18 promotes resistance against black spot disease by activation of the chalcone synthase gene PbCHS3 in pear. Plant Sci. 2024, 341, 112015. [Google Scholar] [CrossRef] [PubMed]
- Xing, C.; Chen, Q.; Qiao, Q.; Gu, S.; Cheng, X.; Dong, H.; Lin, L.; Zhang, F.; Han, C.; Zhang, Z.; et al. PbrWRKY70 increases pear (Pyrus bretschneideri Rehd) black spot disease tolerance by negatively regulating ethylene synthesis via PbrERF1B-2. Plant Sci. 2023, 334, 111773. [Google Scholar] [CrossRef] [PubMed]
- Chen, Y.H.; Wu, Y.Z.; Liu, Q.; Xia, Z.; Wang, J.; Luo, X.X. Streptomyces tamarix sp. nov.: Antagonism against Alternaria gaisen producing streptochlorin, isolated from Tamarix root soil. Front. Microbiol. 2023, 14, 1273842. [Google Scholar] [CrossRef] [PubMed]
- Zhou, Z.B. Occurrence pattern and control measures of pear black spot disease. Hebei Fruit Tree 2019, 22+30. [Google Scholar] [CrossRef]
- Chen, X.F. Current status and prospects of research on red Jujube black spot. Agric. Sci. 2013, 141–144. [Google Scholar]
- Dale, J.; James, A.; Paul, J.Y.; Khanna, H.; Smith, M.; Peraza-Echeverria, S.; Garcia-Bastidas, F.; Kema, G.; Waterhouse, P.; Mengersen, K.; et al. Transgenic Cavendish bananas with resistance to Fusarium wilt tropical race 4. Nat. Commun. 2017, 8, 1496. [Google Scholar] [CrossRef]
- Hu, D.; Chen, Y.; Sun, C.; Jin, T.; Fan, G.; Liao, Q.; Mok, K.M.; Lee, M.S. Genome guided investigation of antibiotics producing actinomycetales strain isolated from a Macau mangrove ecosystem. Sci. Rep. 2018, 8, 14271. [Google Scholar] [CrossRef]
- Ferreira-Pinto, M.M.; Moura-Guedes, M.C.; Barreiro, M.G.; Pais, I.; Santos, M.R.; Silva, M.J. Aureobasidium pullulansas a biocontrol agent of blue mold in “Rocha” pear. Commun. Agric Appl. Biol. Sci. 2006, 71 3 Pt B, 973–978. [Google Scholar]
- Adra, C.; Tran, T.D.; Foster, K.; Tomlin, R.; Kurtböke, D.İ. Identification of acetomycin as an antifungal agent produced by termite gut-associated Streptomycetes against Pyrrhoderma noxium. Antibiotics 2024, 13, 45. [Google Scholar] [CrossRef]
- Kong, Y.; Xu, X.; Zhu, L. Cyanobactericidal effect of Streptomyces sp. HJC-D1 on microcystis auruginosa. PLoS ONE 2013, 8, e57654. [Google Scholar] [CrossRef]
- Minnikin, D.E. An integrated procedure for the extraction of bacterial isoprenoid quinones and polar lipids. J. Microbiol. Methods 1984, 2, 233–241. [Google Scholar] [CrossRef]
- Avula, B.; Wang, Y.H.; Pawar, R.S.; Shukla, Y.J.; Smillie, T.J.; Khan, I.A. A rapid method for chemical fingerprint analysis of Hoodia species, related genera, and dietary supplements using UPLC-UV-MS. J. Pharm. Biomed. Anal. 2008, 48, 722–731. [Google Scholar] [CrossRef]
- Yoon, S.H.; Ha, S.M.; Kwon, S.; Lim, J.; Kim, Y.; Seo, H.; Chun, J. Introducing EzBioCloud: A taxonomically united database of 16S rRNA gene sequences and whole-genome assemblies. Int. J. Syst. Evol. Microbiol. 2017, 67, 1613–1617. [Google Scholar] [CrossRef] [PubMed]
- Esmaeel, Q.; Pupin, M.; Kieu, N.P.; Chataigné, G.; Béchet, M.; Deravel, J.; Krier, F.; Höfte, M.; Jacques, P.; Leclère, V. Burkholderia genome mining for nonribosomal peptide synthetases reveals a great potential for novel siderophores and lipopeptides synthesis. Microbiologyopen 2016, 5, 512–526. [Google Scholar] [CrossRef]
- Kodani, S.; Komaki, H.; Ishimura, S.; Hemmi, H.; Ohnishi-Kameyama, M. Isolation and structure determination of a new lantibiotic cinnamycin B from Actinomadura atramentaria based on genome mining. J. Ind. Microbiol. Biotechnol. 2016, 43, 1159–1165. [Google Scholar] [CrossRef] [PubMed]
- Nowak, K.; Ratajczak-Wrona, W.; Górska, M.; Jabłońska, E. Parabens and their effects on the endocrine system. Mol. Cell Endocrinol. 2018, 474, 238–251. [Google Scholar] [CrossRef]
- Chen, E.; Chen, Q.; Chen, S.; Xu, B.; Ju, J.; Wang, H. Mathermycin, a Lantibiotic from the Marine Actinomycete Marinactinospora thermotolerans SCSIO 00652. Appl. Environ. Microbiol. 2017, 83, e00926-17. [Google Scholar] [CrossRef]
- Vadankula, G.R.; Nilkanth, V.V.; Rizvi, A.; Yandrapally, S.; Agarwal, A.; Chirra, H.; Biswas, R.; Arifuddin, M.; Nema, V.; Mallika, A.; et al. Confronting Tuberculosis: A Synthetic Quinoline-Isonicotinic Acid Hydrazide Hybrid Compound as a Potent Lead Molecule Against Mycobacterium tuberculosis. ACS Infect. Dis. 2024, 10, 2288–2302. [Google Scholar] [CrossRef]
- Yang, X.; Shu, Y.; Cao, S.; Sun, H.; Zhang, X.; Zhang, A.; Li, Y.; Ma, D.; Chen, H.; Li, W. Trehalase inhibitor validamycin may have additional mechanisms of toxicology against rhizoctonia cerealis. J. Fungi 2023, 9, 846. [Google Scholar] [CrossRef]
- Qi, D.; Zou, L.; Zhou, D.; Chen, Y.; Gao, Z.; Feng, R.; Zhang, M.; Li, K.; Xie, J.; Wang, W. Taxonomy and broad-spectrum antifungal activity of Streptomyces sp. SCA3-4 isolated from Rhizosphere soil of Opuntia stricta. Front. Microbiol. 2019, 10, 1390. [Google Scholar] [CrossRef]
- Telek, A.; Molnár, Z.; Takács, K.; Varga, B.; Grolmusz, V.; Tasnádi, G.; Vértessy, B.G. Discovery and biocatalytic characterization of opine dehydrogenases by metagenome mining. Appl. Microbiol. Biotechnol. 2024, 108, 101. [Google Scholar] [CrossRef] [PubMed]
- Torrents-Masoliver, B.; Terriente-Palacios, C.; Bover-Cid, S.; Jofré, A.; Castellari, M.; Ribas-Agustí, A. Effect of pH and temperature on tropane alkaloids within a processing strategy to provide safe infant cereal-based food. Food Res. Int. 2024, 188, 114439. [Google Scholar] [CrossRef] [PubMed]
- Boone, C.J.; Pine, L. Rapid method for characterization of actinomycetes by cell wall composition. Appl. Microbiol. 1968, 16, 279–284. [Google Scholar] [CrossRef]
- Mo, P.; Wu, C.; Han, R.; Chen, Z.; Luo, Y.; Xie, P.; Li, L.; Wang, Y. Streptomyces cathayae sp. nov., an endophytic actinobacterium from the root tissue of Cathaya argyrophylla. Antonie Van Leeuwenhoek 2024, 117, 31. [Google Scholar] [CrossRef] [PubMed]
- Zhou, Z.; Charlesworth, J.; Achtman, M. Accurate reconstruction of bacterial pan- and core genomes with PEPPAN. Genome Res. 2020, 30, 1667–1679. [Google Scholar] [CrossRef]
- Saitou, N.; Nei, M. The neighbor-joining method: A new method for reconstructing phylogenetic trees. Mol. Biol. Evol. 1987, 4, 406–425. [Google Scholar] [CrossRef]
- Tohtahun, K.; Kong, D.; Chai, L.; Mulati, M.; Zhao, X.; Dong, X.; Zhang, W. Diversity and growth-promoting characteristics of rhizosphere bacteria of three naturally growing plants at the sand iron ore restoration area in Qinghe county. Sci. Total Environ. 2024, 930, 172654. [Google Scholar] [CrossRef]
- McCarthy, A.J.; Williams, S.T. Actinomycetes as agents of biodegradation in the environment—A review. Gene 1992, 115, 189–192. [Google Scholar] [CrossRef]
- Blin, K.; Shaw, S.; Medema, M.H.; Weber, T. The antiSMASH database version 4: Additional genomes and BGCs, new sequence-based searches and more. Nucleicacids Res. 2023, 52, D586–D589. [Google Scholar] [CrossRef]
- Jaarsma, A.H.; Zervas, A.; Sipes, K.; Campuzano Jiménez, F.; Smith, A.C.; Svendsen, L.V.; Thøgersen, M.S.; Stougaard, P.; Benning, L.G.; Tranter, M.; et al. The undiscovered biosynthetic potential of the greenland Ice sheet microbiome. Front. Microbiol. 2023, 14, 1285791. [Google Scholar] [CrossRef]
- Abdul Wadud, M.; Das, S.; Atiqur Rahman Khokon, M. Prevalence of the Alternaria blight of cumin (Cuminum cyminum L.) in Bangladesh: Morphology, phylogeny and pathogenic variation of Alternaria spp. Saudi J. Biol. Sci. 2021, 28, 5865–5874. [Google Scholar] [CrossRef] [PubMed]
- Šutovská, M.; Kocmálová, M.; Mažerik, J.; Pawlaczyk-Graja, I.; Gancarz, R.; Capek, P. Chemical characteristics and significant antitussive effect of the Erigeron canadensis polyphenolic polysaccharide-protein complex. J. Ethnopharmacol. 2022, 284, 114754. [Google Scholar] [CrossRef] [PubMed]
- Jaeger Greer, M.R.; Cates, R.G.; Johnson, F.B.; Lamnaouer, D.; Ohai, L. Activity of acetone and methanol extracts from thirty-one medicinal plant species against herpes simplex virus types 1 and 2. Pharm. Biol. 2010, 48, 1031–1037. [Google Scholar] [CrossRef]
- Quintieri, L.; Palumbo, M.; Ricci, I.; Pace, B.; Caputo, L.; Adduci, A.; Luparelli, A.; Cefola, M.; Siano, F.; Cozzolino, R. Postharvest quality of citrus medica L. (cv Liscia-Diamante) fruit Stored at different temperatures: Volatile profile and antimicrobial activity of essential oils. Foods 2024, 13, 1596. [Google Scholar] [CrossRef]
- El Awady, M.E.; El-Shall, F.N.; Mohamed, G.E.; Abd-Elaziz, A.M.; Abdel-Monem, M.O.; Hassan, M.G. Exploring the decolorization efficiency and biodegradation mechanisms of different functional textile azo dyes by Streptomyces albidoflavus 3MGH. BMC Microbiol. 2024, 24, 210. [Google Scholar] [CrossRef]
- Blumauerová, M.; Lipavská, H.; Stajner, K.; Vanĕk, Z. The study of variability and strain selection in Streptomyces atroolivaceus. III. Isolation and preliminary characteristics of mutants impaired in the biosynthesis of mithramycin. Folia Microbiol. 1976, 21, 285–293. [Google Scholar] [CrossRef] [PubMed]
- Zhu, H.; Ahmad, T.; Zheng, Y.; Moosa, A.; Chengrong, N.; Liu, Y. First report of leaf blight disease of Livistona chinensis caused by Alternaria in Pakistan. Plant Dis. 2022, 106, 2997. [Google Scholar] [CrossRef]
- Shan, W.; Zhou, Y.; Liu, H.; Yu, X. Endophytic actinomycetes from tea plants (Camellia sinensis): Isolation, abundance, antimicrobial, and plant-growth-promoting activities. Biomed. Res. Int. 2018, 1470305. [Google Scholar] [CrossRef]
- Lin, Q.; Li, H.; Liu, Y.L. First report of Neopestalotiopsis clavispora causing guava scab in China. Plant Dis. 2024. [Google Scholar] [CrossRef]
- Wang, J.; Cai, B.; Li, K.; Zhao, Y.; Li, C.; Liu, S.; Xiang, D.; Zhang, L.; Xie, J.; Wang, W. Biological control of Fusarium oxysporum f. sp. cubense tropical race 4 in banana plantlets using newly isolated Streptomyces sp. WHL7 from marine soft coral. Plant Dis. 2022, 106, 254–259. [Google Scholar] [CrossRef]
- Behera, H.T.; Mojumdar, A.; Behera, S.S.; Das, S.; Ray, L. Biocontrol of wilt disease of rice seedlings incited by Fusarium oxysporum through soil application of Streptomyces chilikensis RC1830. Lett. Appl. Microbiol. 2022, 75, 1366–1382. [Google Scholar] [CrossRef] [PubMed]
- Yuan, M.; Yu, Y.; Lian, H.R. Molecular identification, biological activity and optimization of fermentation conditions of marine Actinomycete Y18 and its antimicrobial substances. Polar Res. 2014, 26, 292–299. [Google Scholar] [CrossRef]
- Du, J.; Ma, L.; Ma, A.; Liu, L.; Yu, Q.; Wu, Q. 2011 A study on the development strategy of microbial industry in China. Research on the development strategy of microbial industry in China. Chin. Eng. Sci. 2021, 23, 51–58. [Google Scholar] [CrossRef]
- Xie, F.; Pathom-Aree, W. Actinobacteria From Desert: Diversity and Biotechnological Applications. Front. Microbiol. 2021, 12, 765531. [Google Scholar] [CrossRef]
- Yang, Y.L. Study on the Diversity and Antimicrobial Pro-Life Properties of Inter-Root Actinomycetes of Rhododendron in Gongga Mountain Area. Ph.D. Thesis, Sichuan Agricultural University, Ya’an, China, 2017. [Google Scholar]
- Zhao, K. Diversity and Antimicrobial Activity of Endophytic and Inter-Root Actinomycetes of Medicinal Plants in Western Panxi; Sichuan Agricultural University: Ya’an, China, 2010. [Google Scholar]
- Tou, L.; Xug, R.H.; Guo, L.; Zhang, Y.Q.; Tao, L.; Wang, F.F. Study on the diversity and biological activity of inter-root actinomycetes of sand plants in Lop Nor region. Chin. J. Antibiot. 2012, 37, 21–26. [Google Scholar] [CrossRef]
- Chakravarti, D.N.; Fiske, M.J.; Fletcher, L.D.; Zagursky, R.J. Mining genomes and mapping proteomes: Identification and characterization of protein subunit vaccines. Dev. Biol. 2000, 103, 81–90. [Google Scholar]
- Harris, T.W.; Stein, L.D. WormBase: Methods for data mining and comparative genomics. Methods Mol. Biol. 2006, 351, 31–50. [Google Scholar] [CrossRef]
- Iftime, D.; Jasyk, M.; Kulik, A.; Imhoff, J.F.; Stegmann, E.; Wohlleben, W.; Süssmuth, R.D.; Weber, T. Streptocollin, a Type IV Lanthipeptide Produced by Streptomyces collinus Tü 365. Chembiochem. 2015, 16, 2615–2623. [Google Scholar] [CrossRef] [PubMed]
- Tudi, M.; Daniel Ruan, H.; Wang, L.; Lyu, J.; Sadler, R.; Connell, D.; Chu, C.; Phung, D.T. Agriculture Development, Pesticide Application and Its Impact on the Environment. Int. J. Environ. Res. Public Health 2021, 18, 1112. [Google Scholar] [CrossRef]
- Chen, Y.; Zhou, D.; Qi, D.; Gao, Z.; Xie, J.; Luo, Y. Growth promotion and disease suppression ability of a Streptomyces sp. CB-75 from banana Rhizosphere Soil. Front. Microbiol. 2018, 8, 2704. [Google Scholar] [CrossRef]
- Dhakar, K.; Pandey, A. Wide pH range tolerance in extremophiles: Towards understanding an important phenomenon for future biotechnology. Appl. Microbiol. Biotechnol. 2016, 100, 2499–2510. [Google Scholar] [CrossRef] [PubMed]
- Bhat, M.P.; Nayaka, S. Cave Soil Streptomyces sp. strain YC69 antagonistic to chilli fungal pathogens exhibits in vitro anticancer activity against Human cervical cancer cells. Appl. Biochem. Biotechnol. 2023, 195, 6232–6255. [Google Scholar] [CrossRef] [PubMed]
- Gong, Y.; Liu, J.Q.; Xu, M.J.; Zhang, C.M.; Gao, J.; Li, C.G.; Xing, K.; Qin, S. Antifungal volatile organic compounds from Streptomyces setonii WY228 control blackspot disease of sweet potato. Appl. Environ. Microbiol. 2022, 88, e0231721. [Google Scholar] [CrossRef] [PubMed]
- Bhat, M.P.; Nayaka, S.; Kumar, R.S. A swamp forest Streptomyces sp. strain KF15 with broad spectrum antifungal activity against chilli pathogens exhibits anticancer activity on HeLa cells. Arch. Microbiol. 2022, 204, 540. [Google Scholar] [CrossRef]
- Jing, T.; Zhou, D.; Zhang, M.; Yun, T.; Qi, D.; Wei, Y.; Chen, Y.; Zang, X.; Wang, W.; Xie, J. Newly isolated Streptomyces sp. JBS5-6 as a potential biocontrol agent to control banana Fusarium Wilt: Genome sequencing and secondary metabolite cluster profiles. Front. Microbiol. 2020, 11, 602591. [Google Scholar] [CrossRef]
- Procópio, R.E.; Silva, I.R.; Martins, M.K.; Azevedo, J.L.; Araújo, J.M. Antibiotics produced by Streptomyces. Braz. J. Infect. Dis. 2012, 16, 466–471. [Google Scholar] [CrossRef]
- Jain, R.; Pandey, A. A phenazine-1-carboxylic acid producing polyextremophilic Pseudomonas chlororaphis (MCC2693) strain, isolated from mountain ecosystem, possesses biocontrol and plant growth promotion abilities. Microbiol. Res. 2016, 190, 63–71. [Google Scholar] [CrossRef]
- Yao, Y.; You, J.; Ou, Y.; Ma, J.; Wu, X.; Xu, G. Ultraviolet-B protection of ascorbate and tocopherol in plants related with their function on the stability on carotenoid and phenylpropanoid compounds. Plant Physiol. Biochem. 2015, 90, 23–31. [Google Scholar] [CrossRef]
- Santos, L.H.; Caffarena, E.R.; Ferreira, R.S. pH and non-covalent ligand binding modulate Zika virus NS2B/NS3 protease binding site residues: Discoveries from MD and constant pH MD simulations. J. Biomol. Struct. Dyn. 2022, 40, 10359–10372. [Google Scholar] [CrossRef]

| Feature | TRM76147 | Streptomyces griseoviridis NBRC12874T | Streptomyces niveoruber NBRC15428T |
|---|---|---|---|
| Color of aerial hyphae | White | Pale greyish-purple | Ivory |
| Matrix hyphal color | Yellow | Purplish-red | Pale yellow |
| Spore chain morphology | Straight | Rectiflexibiles | Straight |
| Pigment production | Yellow | None | Brown |
| Temperature range (°C) | 20–45 | ≤45 | <45 |
| pH range | 7–10 | 5–12 | 6–11 |
| NaCl range (%) | ≤5 | ≤7 | <7 |
| Sucrose | + | ND | ND |
| Maltose | + | + | + |
| L-arabinose | + | (+) | + |
| Galactose | + | ND | ND |
| Lactose | ND | + | (+) |
| Inositol | + | + | ND |
| Dextrin | + | + | ND |
| Melanin production | − | − | − |
| Hydrogen sulfide production | + | − | − |
| Gelatin liquefaction | + | + | + |
| Protease production | + | + | − |
| Amylase production | + | ND | ND |
| Nitrate reduction | + | ND | ND |
| Oxidase production | + | ND | ND |
| Production of catalase | + | ND | ND |
| Urease production | − | ND | ND |
| Tween 20 | + | + | + |
| Cellulose decomposition | + | ND | ND |
Disclaimer/Publisher’s Note: The statements, opinions and data contained in all publications are solely those of the individual author(s) and contributor(s) and not of MDPI and/or the editor(s). MDPI and/or the editor(s) disclaim responsibility for any injury to people or property resulting from any ideas, methods, instructions or products referred to in the content. |
© 2024 by the authors. Licensee MDPI, Basel, Switzerland. This article is an open access article distributed under the terms and conditions of the Creative Commons Attribution (CC BY) license (https://creativecommons.org/licenses/by/4.0/).
Share and Cite
Chen, Y.-H.; Zhang, J.-X.; Yang, G.; Liu, Y.; Ran, S.; Wang, J.-M.; Liu, Q.; Luo, X.-X. Potential of Crude Extract of Streptomyces sp. nov., Strain TRM76147 for Control of A. gaisen. Forests 2024, 15, 1605. https://doi.org/10.3390/f15091605
Chen Y-H, Zhang J-X, Yang G, Liu Y, Ran S, Wang J-M, Liu Q, Luo X-X. Potential of Crude Extract of Streptomyces sp. nov., Strain TRM76147 for Control of A. gaisen. Forests. 2024; 15(9):1605. https://doi.org/10.3390/f15091605
Chicago/Turabian StyleChen, Yi-Huang, Jia-Xin Zhang, Guo Yang, Yang Liu, Song Ran, Jian-Ming Wang, Qin Liu, and Xiao-Xia Luo. 2024. "Potential of Crude Extract of Streptomyces sp. nov., Strain TRM76147 for Control of A. gaisen" Forests 15, no. 9: 1605. https://doi.org/10.3390/f15091605
APA StyleChen, Y.-H., Zhang, J.-X., Yang, G., Liu, Y., Ran, S., Wang, J.-M., Liu, Q., & Luo, X.-X. (2024). Potential of Crude Extract of Streptomyces sp. nov., Strain TRM76147 for Control of A. gaisen. Forests, 15(9), 1605. https://doi.org/10.3390/f15091605





